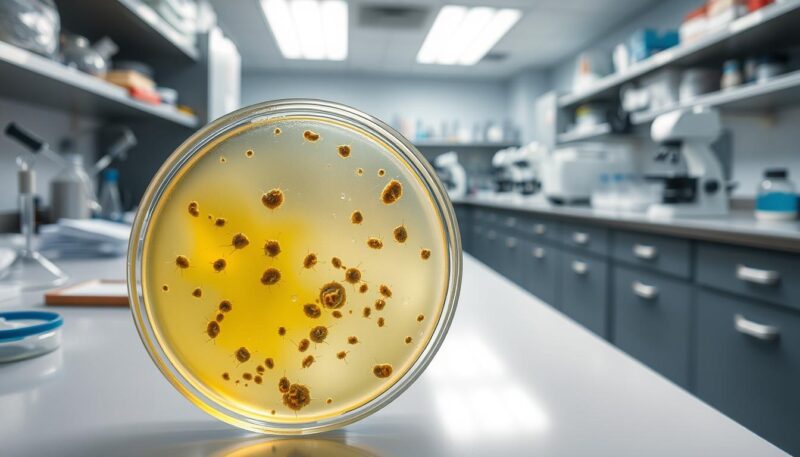
Mikrobiološka analiza urina

Mikrobiološke analize urina i briseva su ključne dijagnostičke metode koje omogućavaju identifikaciju uzročnika različitih infekcija. Ove analize pružaju lekarima neophodne informacije za postavljanje precizne dijagnoze i određivanje adekvatne terapije.
Razumevanje vrste bakterija i drugih mikroorganizama koji izazivaju infekcije je od suštinskog značaja za efikasno lečenje pacijenata. Rezultati ovih analiza omogućavaju lekarima da odrede pravi med za lečenje.
U ovom članku, detaljno ćemo objasniti šta su mikrobiološke analize, kako se pravilno uzimaju uzorci i koje informacije pružaju rezultati.
Osnove mikrobiologije i njen značaj u medicini
Mikrobiologija je nauka koja se bavi proučavanjem mikroorganizama, njihovih karakteristika i uloge u različitim procesima. Mikrobiologija kao posebna nauka proučava mikroorganizme, koji su sastavni deo životne zajednice na našoj planeti.
Definicija i predmet izučavanja mikrobiologije
Mikrobiologija se kao jedna od bioloških nauka odvojila od biologije u zasebnu naučnu disciplinu. Predmet izučavanja mikrobiologije su mikroorganizmi, koji uključuju različite vrste bakterija, virusa, gljiva i parazita. Ovi mikroorganizmi su svuda oko nas i imaju značajan uticaj na naše zdravlje i životnu sredinu.
Mikroorganizmi su raznovrsni i mogu biti korisni ili štetni. Neke vrste mikroorganizama su neophodne za naše zdravlje, dok druge mogu izazvati teške infekcije i bolesti.
Istorijski razvoj mikrobioloških analiza
Istorija mikrobiologije seže u prošlost, kada su prvi mikroskopi omogućili otkriće mikroorganizama. Razvoj mikrobioloških analiza je bio postupan, od prvih jednostavnih mikroskopa do savremenih molekularnih metoda.
Savremene mikrobiološke laboratorije koriste različite tehnike za identifikaciju i karakterizaciju mikroorganizama. Ove laboratorije su ključne za dijagnostiku i lečenje infektivnih bolesti.
Uloga mikrobiologije u savremenoj medicini
Mikrobiologija ima ključnu ulogu u savremenoj medicini. Omogućava identifikaciju uzročnika infekcija, praćenje širenja zaraznih bolesti i razvoj efikasnih terapijskih pristupa. Mikrobiološke laboratorije predstavljaju dijagnostičke centre u zdravstvenim ustanovama, gde se vrše analize različitih uzoraka.
Rezultati mikrobioloških analiza direktno utiču na izbor odgovarajuće antibiotske terapije, što je posebno važno u eri rastuće rezistencije bakterija na antibiotike. Mikrobiologija takođe ima važnu ulogu u prevenciji bolničkih infekcija kroz praćenje prisustva patogenih mikroorganizama i implementaciju mera za sprečavanje njihovog širenja.
Savremene molekularne metode u mikrobiologiji omogućavaju brzu i preciznu identifikaciju uzročnika infekcija, što je od presudnog značaja za pravovremeno započinjanje adekvatne terapije, posebno kod teških i životno ugrožavajućih infekcija.
Mikroorganizmi i njihove karakteristike
U svetu mikroorganizama, postoji neverovatna raznolikost koja utiče na naše živote. Mikroorganizmi su mikroskopski organizmi koji uključuju bakterije, viruse, gljive i parazite. Oni su sveprisutni i nalaze se u različitim sredinama, od ljudskog tela do zemljišta i vode.
Vrste mikroorganizama
Mikroorganizmi se mogu klasifikovati u nekoliko glavnih grupa: bakterije, virusi, gljive i paraziti. Bakterije su prokariotski organizmi koji se mogu naći u različitim sredinama. Virusi su obligatni paraziti koji se razmnožavaju unutar ćelija domaćina. Gljive su eukariotski organizmi koji uključuju kvasce i plesni, a igraju važnu ulogu u razgradnji organske materije.
| Vrsta mikroorganizma | Karakteristike | Primeri |
|---|---|---|
| Bakterije | Prokariotski, ćelije bez jedra | Escherichia coli, Staphylococcus aureus |
| Virusi | Obligatni paraziti, nemaju ćelijsku strukturu | Influenzavirus, HIV |
| Gljive | Eukariotski, uključuju kvasce i plesni | Candida albicans, Aspergillus fumigatus |
Morfologija i struktura mikroorganizama
Morfologija i struktura mikroorganizama variraju među različitim grupama. Bakterije mogu biti različitih oblika, kao što su kokni, bacili i spirale. Virusi imaju karakterističnu strukturu koja uključuje kapsid i eventualno lipidnu ovojnicu. Gljive imaju eukariotsku strukturu sa jedrom i drugim organelama.
Životni ciklus i razmnožavanje mikroorganizama
Životni ciklus mikroorganizama obuhvata nekoliko faza, uključujući lag fazu, log fazu, stacionarnu fazu i fazu odumiranja. Bakterije se razmnožavaju aseksualnim putem kroz binarnu fisiju. Gljive se mogu razmnožavati i seksualno i aseksualno. Virusi se razmnožavaju unutar ćelija domaćina koristeći njihov metabolički aparat.
- Životni ciklus mikroorganizama uključuje prilagođavanje, eksponencijalni rast, ravnotežu i odumiranje.
- Razmnožavanje bakterija se odvija kroz binarnu fisiju.
- Gljive se razmnožavaju putem pupljenja ili stvaranjem spora.
- Virusi koriste ćelije domaćina za svoju replikaciju.
Razumevanje životnog ciklusa i načina razmnožavanja mikroorganizama je ključno za razvoj efikasnih antimikrobnih lekova i strategija za kontrolu infekcija.
Mikrobiološka laboratorija i oprema
Mikrobiološka laboratorija predstavlja srce dijagnostike infektivnih bolesti, gde se koriste različiti instrumenti i oprema za analizu mikroorganizama. Ova laboratorija je opremljena specijalizovanim uređajima koji omogućavaju preciznu identifikaciju i karakterizaciju mikroorganizama.
Osnovni laboratorijski pribor i instrumenti
Osnovni laboratorijski pribor uključuje mikroskope, termostate, autoklave, i druge instrumente neophodne za mikrobiološke analize. Mikroskopi su ključni za posmatranje mikroorganizama, dok se termostati koriste za kultivaciju bakterija i drugih mikroorganizama.
Mikroskopi i njihova primena u mikrobiologiji
Mikroskopi su neophodni u mikrobiologiji za posmatranje mikroorganizama koji se ne mogu videti golim okom. Postoje različite vrste mikroskopa, uključujući optičke i elektronske mikroskope, svaki sa svojim specifičnim primenama u mikrobiološkim analizama.
Sterilizacija i priprema materijala za analizu
Sterilizacija je proces kojim se uništavaju svi oblici mikroorganizama, što je neophodno za dobijanje pouzdanih rezultata mikrobioloških analiza. Metode sterilizacije uključuju fizičke i hemijske metode. Fizička sterilizacija može se vršiti suvom toplotom, vlažnom toplotom ili zračenjem.
Sterilizacija suvom toplotom koristi se za sterilizaciju staklenog i metalnog pribora, dok je sterilizacija vlažnom toplotom (autoklaviranje) najefikasnija metoda za sterilizaciju hranljivih podloga i termostabilnog pribora.
Uzorkovanje materijala za mikrobiološke analize
Uzorkovanje materijala za mikrobiološke analize predstavlja kritičan korak u dijagnostici infekcija. Pravilno uzorkovanje osigurava da se mikroorganizmi koji izazivaju infekciju identifikuju tačno i na vreme, što je ključno za efikasno lečenje.
Pravilno uzimanje uzoraka urina
Uzimanje uzoraka urina zahteva posebnu pažnju kako bi se izbegla kontaminacija. Prvi jutarnji urin je najpogodniji za analizu jer je koncentrovaniji. Preporučuje se čišćenje genitalnog područja pre uzorkovanja i upotreba sterilnog kontejnera.
Uzorak treba što pre transportovati u laboratoriju, po mogućnosti u roku od 2 sata. Ukoliko to nije moguće, uzorak se može čuvati na temperaturi od 2-8°C do 24 sata.
Tehnike uzimanja briseva
Brisevi se uzimaju sa različitih lokalizacija, kao što su urogenitalni trakt, grlo, nos, ili rane. Tehnika uzimanja briseva mora biti izvedena tako da se minimizira kontaminacija sa okolnih površina.
Za urogenitalne briseve, koristi se sterilni štapić sa pamučnim vrhom koji se pažljivo uvodi u cervikalni kanal ili uretru. Bris se zatim stavlja u transportni medijum koji održava vijabilnost mikroorganizama.
Transport i čuvanje uzoraka
Transport i čuvanje uzoraka su ključni za očuvanje vijabilnosti mikroorganizama i dobijanje pouzdanih rezultata mikrobioloških analiza. Uzorci treba da se transportuju u odgovarajućim transportnim medijumima koji sprečavaju prekomerno razmnožavanje mikroorganizama.
Različiti mikroorganizmi zahtevaju specifične uslove transporta. Na primer, Amies ili Stuart medijum se koristi za bakterije, dok se za gljive koristi Sabouraud medijum. Vreme transporta treba da bude što kraće, optimalno unutar 2 sata od uzorkovanja.
Ako nije moguće transportovati uzorak u roku od 2 sata, većina uzoraka se može čuvati na temperaturi od 2-8°C do 24 sata. Neki uzorci zahtevaju posebne uslove, kao što su anaerobni uslovi za anaerobne bakterije ili transport na ledu za određene viruse.
Mikrobiološka analiza urina
Mikrobiološka analiza urina predstavlja ključni dijagnostički alat u otkrivanju infekcija urinarnog trakta. Ova analiza omogućava identifikaciju mikroorganizama koji uzrokuju infekcije, kao i određivanje njihove osetljivosti na antibiotike. Time se olakšava izbor adekvatne terapije.
Indikacije za mikrobiološku analizu urina
Mikrobiološka analiza urina se preporučuje kod pacijenata sa simptomima infekcija urinarnog trakta, kao što su bol pri uriniranju, česta potreba za uriniranjem i prisustvo krvi u urinu. Takođe, analiza je indicirana kod osoba sa povećanim rizikom od infekcija, poput dijabetičara ili onih sa urološkim abnormalnostima.
Postupak analize i kultivacije urina
Analiza urina uključuje kultivaciju uzorka urina na različitim hranljivim podlogama. Zasejavanje hranljivih podloga, kao što su krvni agar i MacConkey agar, omogućava rast i identifikaciju prisutnih mikroorganizama. Zasejavanje tečnih podloga, poput bujona, koristi se za dodatnu kultivaciju. Aparati za gajenje mikroorganizama, kao što su termostati, održavaju optimalne uslove za rast bakterija.
| Vrsta podloge | Namenjena za | Primeri mikroorganizama |
|---|---|---|
| Krvni agar | Širok spektar bakterija | Staphylococcus aureus, Streptococcus spp. |
| MacConkey agar | Gram-negativne bakterije | Escherichia coli, Klebsiella pneumoniae |
| Bujon | Dodatna kultivacija | Različite vrste bakterija |
Interpretacija rezultata urinokulture
Interpretacija rezultata urinokulture zasniva se na kvantitativnoj i kvalitativnoj analizi. Kvantitativna analiza uključuje određivanje broja bakterija u mililitru urina (CFU/ml), dok kvalitativna analiza podrazumeva identifikaciju vrste bakterija i njihovu osetljivost na antibiotike.
Značajnom bakteriurijom se smatra prisustvo ≥10^5 CFU/ml jedne vrste bakterija u pravilno uzetom uzorku srednjeg mlaza urina. Niži brojevi bakterija mogu biti značajni u određenim kliničkim situacijama.
Prisustvo više vrsta bakterija u uzorku urina često ukazuje na kontaminaciju, osim kod pacijenata sa urinarnim kateterom ili neurološkim poremećajima.
Mikrobiološka analiza briseva
Mikrobiološka analiza briseva predstavlja ključni alat u dijagnostici infekcija. Brisevi se koriste za uzorkovanje materijala iz različitih delova tela, kao što su urogenitalni trakt, grlo, nos, i rane. Ova analiza omogućava identifikaciju mikroorganizama koji uzrokuju infekcije, što je ključno za odabir adekvatne terapije.
Vrste briseva i njihova primena
Postoji nekoliko vrsta briseva koji se koriste u mikrobiologiji, svaki sa specifičnom primenom. Urogenitalni brisevi se koriste za dijagnostiku infekcija urinarnog trakta i genitalnih infekcija. Brisevi grla se koriste za otkrivanje bakterijskih i virusnih infekcija, kao što je streptokokni faringitis. Brisevi rana se koriste za identifikaciju mikroorganizama koji uzrokuju infekcije rana.
Urogenitalni brisevi su posebno važni za dijagnostiku infekcija kao što su hlamidijaza i gonoreja. Ovi brisevi se uzimaju iz uretre, cerviksa ili vagine, zavisno od pola i simptoma pacijenta.
Metode kultivacije i identifikacije mikroorganizama iz briseva
Kultivacija mikroorganizama iz briseva se vrši na hranljivim podlogama koje su posebno dizajnirane za podršku rasta različitih vrsta bakterija i gljivica. Nakon kultivacije, mikroorganizmi se identifikuju na osnovu njihovih morfoloških karakteristika, biohemijskih reakcija i drugih osobina.
Metode identifikacije uključuju mikroskopiju, biohemijske testove i molekularne tehnike kao što je PCR (Polimerazna Lančana Reakcija). PCR omogućava brzu i preciznu identifikaciju patogenih mikroorganizama direktno iz kliničkih uzoraka.
Tumačenje rezultata analize briseva
Tumačenje rezultata analize briseva zahteva integraciju mikrobioloških nalaza sa kliničkom slikom pacijenta. Prisustvo mikroorganizama ne znači uvek i infekciju, jer neki mikroorganizmi mogu biti deo normalne flore.
- Kod urogenitalnih briseva, interpretacija rezultata zavisi od lokalizacije uzorka, pola i starosti pacijenta.
- Rezultati briseva grla tumače se u kontekstu kliničke slike, pri čemu je važno razlikovati kolonizaciju od infekcije.
- Kod briseva rana, interpretacija rezultata uključuje procenu značaja izolovanih mikroorganizama, njihovog broja i vrste, kao i prisustva znakova infekcije na mestu uzorkovanja.
- Antibiogram izolovanih patogenih mikroorganizama predstavlja ključni deo rezultata analize briseva, jer omogućava izbor odgovarajuće antibiotske terapije.
U zaključku, mikrobiološka analiza briseva je nezamenjiv alat u dijagnostici i lečenju infekcija. Pravilna interpretacija rezultata zahteva stručnost i razumevanje kako mikrobioloških nalaza tako i kliničke slike pacijenta.
Hranjive podloge u mikrobiologiji
Hranjive podloge su esencijalne za rast i identifikaciju mikroorganizama u mikrobiološkim laboratorijama. One predstavljaju supstance koje sadrže neophodne nutrijente za rast mikroorganizama, omogućavajući njihovu kultivaciju i dalju analizu.
Vrste hranljivih podloga
Postoji više vrsta hranljivih podloga koje se koriste u mikrobiologiji, svaka sa specifičnim karakteristikama i namenom. Neke od najčešće korišćenih podloga uključuju:
- Čvrste podloge (agar podloge)
- Tečne podloge (bujon)
- Selektivne podloge
- Diferencijalne podloge
Čvrste podloge, kao što su agar podloge, omogućavaju izolaciju pojedinačnih kolonija mikroorganizama, što je ključno za identifikaciju i dalju analizu. Tečne podloge, poput bujona, se koriste za brzi rast velikog broja mikroorganizama.
Priprema i upotreba hranljivih podloga
Priprema hranljivih podloga zahteva pažnju na detalje kako bi se osigurala njihova sterilnost i adekvatna ishrana za mikroorganizme. Proces pripreme uključuje:
- Odmeravanje i mešanje sastojaka
- Sterilizaciju putem autoklaviranja ili filtracije
- Raspoređivanje u sterilne posude
Podloge se čuvaju u sterilnim uslovima do upotrebe. Kada se koriste, podloge se inokuliraju sa uzorkom koji sadrži mikroorganizme i inkubiraju na odgovarajućoj temperaturi.
Selektivne i diferencijalne podloge
Selektivne podloge sadrže supstance koje inhibiraju rast određenih mikroorganizama, omogućavajući selektivni rast ciljanih vrsta. Diferencijalne podloge omogućavaju razlikovanje mikroorganizama na osnovu njihovih biohemijskih karakteristika.
| Vrsta podloge | Primer | Namena |
|---|---|---|
| Selektivna | MacConkey agar | Selektivni rast gram-negativnih bakterija |
| Diferencijalna | Blood agar | Razlikovanje bakterija na osnovu hemolize |
| Kombinovana | XLD agar | Selektivna izolacija i diferencijacija Salmonella i Shigella |
U mikrobiologiji, kombinacija različitih tipova hranljivih podloga omogućava sveobuhvatnu analizu mikroorganizama. Razumevanje karakteristika i primene ovih podloga je ključno za preciznu identifikaciju i karakterizaciju mikroorganizama.
Metode identifikacije mikroorganizama
Postoji više metoda za identifikaciju mikroorganizama, uključujući mikroskopske, biohemijske i molekularne tehnike. Ove metode omogućavaju preciznu identifikaciju mikroorganizama, što je ključno za dijagnostiku i lečenje infekcija.
Mikroskopske metode identifikacije
Mikroskopske metode su jedne od najstarijih tehnika identifikacije mikroorganizama. Ove metode uključuju upotrebu mikroskopa za posmatranje morfologije i strukture mikroorganizama.
Mikroskopija omogućava direktno posmatranje mikroorganizama, što može dati informacije o njihovoj veličini, obliku i načinu kretanja.
Biohemijske metode identifikacije
Biohemijske metode identifikacije mikroorganizama zasnivaju se na analizi njihovih metaboličkih aktivnosti. Ove metode uključuju određivanje sposobnosti mikroorganizama da vrše određene biohemijske reakcije.
- Određivanje hidrolize skroba
- Hidroliza kazeina
- Otapanje — likvefacija želatina
- Stvaranje indola
- Stvaranje sumporovodika
- Redukcija nitrata
- Redukcija vodonik-peroksida
- Fermentacija ugljenih hidrata
Ove biohemijske karakteristike su važne za identifikaciju bakterija i drugih mikroorganizama.
Molekularne metode identifikacije
Molekularne metode identifikacije mikroorganizama su zasnovane na analizi nukleinskih kiselina (DNK ili RNK). Ove metode su veoma precizne i omogućavaju identifikaciju mikroorganizama na nivou vrste ili soja.
Lančana reakcija polimeraze (PCR) je jedna od najčešće korišćenih molekularnih metoda. PCR omogućava amplifikaciju specifičnih segmenata DNK mikroorganizama, što omogućava njihovu detekciju čak i kada su prisutni u malom broju ili nisu vijabilni.
Real-time PCR predstavlja unapređenu verziju PCR metode koja omogućava kvantifikaciju mikroorganizama u realnom vremenu. Ova metoda je posebno važna za praćenje virusnih infekcija poput HIV-a ili hepatitisa C.
Sekvenciranje DNK, posebno 16S rRNK gena kod bakterija, omogućava preciznu identifikaciju vrsta na osnovu poređenja dobijenih sekvenci sa bazama podataka poznatih mikroorganizama.
Antibiogram i testiranje osetljivosti na antibiotike
Antibiogram je ključni alat u mikrobiologiji koji omogućava određivanje osetljivosti mikroorganizama na antibiotike. Ova analiza je neophodna za izbor adekvatne antibiotske terapije, posebno kod teških infekcija gde je pravovremeno i efikasno lečenje ključno.
Testiranje osetljivosti mikroorganizama na antibiotike putem antibiograma se izvodi u mikrobiološkim laboratorijama. Ovaj proces uključuje izlaganje izolovanih mikroorganizama različitim antibioticima i posmatranje njihovog rasta ili inhibicije.
Principi izrade antibiograma
Izrada antibiograma se zasniva na principu difuzije antibiotika u čvrstom hranljivom mediju. Bakterije se zaseju na površinu agara, a zatim se postavljaju diskovi natopljeni različitim antibioticima. Nakon inkubacije, zone inhibicije oko diskova se mere i upoređuju sa standardnim vrednostima kako bi se odredila osetljivost ili rezistencija bakterija na testirane antibiotike.
Interpretacija rezultata antibiograma
Interpretacija antibiograma zahteva stručnost i poznavanje kliničkog konteksta. Rezultati se tumače kao osetljiv (S), umereno osetljiv (I), ili rezistentan (R) na određeni antibiotik. Ova interpretacija pomaže lekarima da izaberu najpogodniji antibiotik za lečenje infekcije.
| Antibiotik | Rezultat | Interpretacija |
|---|---|---|
| Penicilin | S | Osjetljiv |
| Gentamicin | R | Rezistentan |
| Ciprofloxacin | I | Umereno osetljiv |
Značaj antibiograma u izboru terapije
Antibiogram ima ključnu ulogu u izboru ciljane antibiotske terapije. Omogućava primenu antibiotika na koji je uzročnik infekcije osetljiv, što povećava efikasnost lečenja i smanjuje rizik od neželjenih efekata. Kod teških infekcija, empirijska terapija se započinje pre dobijanja rezultata antibiograma, ali se nakon dobijanja rezultata terapija može korigovati u skladu sa osetljivošću uzročnika.
Praćenje rezultata antibiograma na nivou zdravstvene ustanove ili regiona omogućava kreiranje lokalnih smernica za empirijsku antibiotsku terapiju, što je važan element strategije za kontrolu antimikrobne rezistencije.
Najčešći patogeni mikroorganizmi u urinu
Infekcije urinarnog trakta predstavljaju značajan zdravstveni problem zbog raznovrsnosti uzročnika. Ove infekcije mogu biti uzrokovane različitim vrstama mikroorganizama, uključujući bakterije, gljive i viruse. Razumevanje ovih patogena je ključno za dijagnostiku i lečenje.
Bakterije kao uzročnici urinarnih infekcija
Bakterije su najčešći uzročnici urinarnih infekcija. Escherichia coli je odgovorna za većinu slučajeva, dok druge bakterije kao što su Klebsiella pneumoniae i Proteus mirabilis takođe mogu biti uzročnici. Ove bakterije mogu izazvati različite kliničke manifestacije, od asimptomatske bakteriurije do teških oblika pijelonefritisa.
Važno je napomenuti da je pravilna identifikacija bakterijskog uzročnika ključna za odabir adekvatne antibiotske terapije. U tu svrhu se koriste različite mikrobiološke tehnike, uključujući kultivaciju i testiranje osetljivosti na antibiotike.
Gljivične infekcije urinarnog trakta
Gljivične infekcije urinarnog trakta su manje česte u odnosu na bakterijske, ali mogu predstavljati ozbiljan zdravstveni problem, posebno kod imunokompromitovanih pacijenata. Candida albicans je najčešći gljivični patogen urinarnog trakta. Ove infekcije mogu biti asimptomatske ili se manifestovati kao cistitis ili pijelonefritis.
Dijagnostika gljivičnih infekcija zahteva mikrobiološku analizu urina, uključujući kultivaciju i identifikaciju gljivica. Lečenje se obično zasniva na antifungalnoj terapiji.
Virusne infekcije urinarnog trakta
Virusne infekcije urinarnog trakta su relativno retke u poređenju sa bakterijskim i gljivičnim infekcijama, ali mogu imati značajne kliničke manifestacije, posebno kod imunokompromitovanih pacijenata. Neki od najznačajnijih virusnih patogena uključuju:
- BK virus (poliomavirus), koji može izazvati nefropatiju kod pacijenata sa transplantiranim bubregom.
- Adenovirusi, koji mogu uzrokovati hemoragični cistitis, posebno kod dece i imunokompromitovanih pacijenata.
- Citomegalovirus (CMV), koji retko direktno inficira urinarni trakt, ali može izazvati intersticijalni nefritis kod imunokompromitovanih pacijenata.
Dijagnostika virusnih infekcija urinarnog trakta zahteva specifične metode poput PCR-a, kultivacije virusa ili detekcije virusnih antigena, jer se virusi ne mogu detektovati standardnom urinokulturom.
Najčešći patogeni mikroorganizmi u brisevima
U mikrobiologiji, brisevi predstavljaju važan materijal za analizu i identifikaciju patogenih mikroorganizama. Oni se koriste za uzorkovanje različitih lokalizacija na telu, kao što su koža, sluzokoža, rane, i druge površine. Analiza briseva omogućava zdravstvenim radnicima da odrede vrstu infekcije i odaberu adekvatnu terapiju.
Bakterije u brisevima različitih lokalizacija
Bakterije su česti uzročnici infekcija koje se mogu dijagnostikovati analizom briseva. Različite vrste bakterija mogu biti prisutne na različitim lokalizacijama, kao što su koža, sluzokoža, i rane. Na primer, Staphylococcus aureus je čest uzročnik kožnih infekcija, dok Neisseria gonorrhoeae može biti prisutan u urogenitalnim brisevima.
Identifikacija bakterija iz briseva uključuje kultivaciju na hranljivim podlogama, bojenje po Gramu, i biohemijske testove. Ovi postupci omogućavaju preciznu identifikaciju bakterija i određivanje njihove osetljivosti na antibiotike.
| Vrsta bakterije | Lokalizacija | Klinička prezentacija |
|---|---|---|
| Staphylococcus aureus | Koža, rane | Apscesi, furunkuli |
| Neisseria gonorrhoeae | Urogenitalni trakt | Gonoreja |
| Streptococcus pyogenes | Grlo, koža | Faringitis, impetigo |
Gljivične infekcije kože i sluzokože
Gljivične infekcije su takođe česte i mogu biti dijagnostikovane analizom briseva. Candida vrste su među najčešćim uzročnicima gljivičnih infekcija kože i sluzokože. Ove infekcije mogu biti prisutne u različitim oblicima, kao što su oralna kandidijaza, vaginalna kandidijaza, i kožne lezije.
Identifikacija gljivica uključuje mikroskopski pregled, kultivaciju na specijalnim podlogama, i biohemijske testove. Pravilna identifikacija gljivičnih infekcija je važna za odabir adekvatne antifungalna terapije.

Virusne infekcije identifikovane iz briseva
Virusne infekcije često zahvataju kožu i sluzokože, a njihova dijagnostika može uključivati uzimanje briseva za specifične virusološke analize. Na primer, Herpes simplex virus (HSV-1 i HSV-2) uzrokuje karakteristične vezikularne lezije na koži i sluzokoži, a dijagnostikuje se iz briseva lezija PCR metodom ili detekcijom virusnih antigena.
- Humani papiloma virus (HPV) je uzročnik genitalnih bradavica i cervikalne displazije, a njegova detekcija iz cervikalnih briseva predstavlja važan skrining metod za prevenciju karcinoma grlića materice.
- Varicella-zoster virus (VZV) uzrokuje varičelu i herpes zoster, a može se detektovati iz briseva vezikularne tečnosti PCR metodom ili detekcijom virusnih antigena.
- Respiratorni virusi kao što su influenca, RSV, adenovirusi, i rinovirusi mogu se detektovati iz nazofaringealnih briseva brzim antigenskim testovima ili PCR metodama, što je posebno važno u sezoni respiratornih infekcija.
Dijagnostika virusnih infekcija iz briseva je ključna za pravilno lečenje i prevenciju daljeg širenja infekcije.
Infekcije urinarnog trakta – dijagnostika i lečenje
Infekcije urinarnog trakta predstavljaju značajan zdravstveni problem koji zahteva pravovremenu dijagnostiku i adekvatno lečenje. Ove infekcije mogu varirati od asimptomatskih do teških kliničkih slika koje zahtevaju hitnu medicinsku intervenciju.
Klinička slika urinarnih infekcija
Klinička prezentacija urinarnih infekcija može biti različita, u zavisnosti od lokalizacije i težine infekcije. Simptomi mogu uključivati disuriju, učestalu potrebu za mokrenjem, bol u donjem delu trbuha, i u težim slučajevima, pijelonefritis sa visokom temperaturom i bolom u slabinskoj regiji.
Simptomi urinarnih infekcija mogu biti različiti kod muškaraca i žena, kao i kod dece i starijih osoba. Kod žena, nekomplikovane urinarne infekcije su česte i obično se manifestuju sa disurijom i učestalom mokrenjem.
Dijagnostički algoritam
Dijagnostika urinarnih infekcija se zasniva na kombinaciji kliničke slike, laboratorijskih nalaza, uključujući urinokulturu i analizu urina. Urinokultura je zlatni standard za dijagnostiku urinarnih infekcija, omogućavajući identifikaciju uzročnika i određivanje antibiotske osetljivosti.
| Dijagnostički test | Opis | Značaj |
|---|---|---|
| Analiza urina | Određivanje prisustva leukocita, nitrita, i drugih parametara | Indikacija za prisustvo infekcije |
| Urinokultura | Kultivacija urina za identifikaciju mikroorganizama | Definitivna dijagnoza i određivanje antibiotske osetljivosti |
Principi lečenja na osnovu mikrobioloških nalaza
Lečenje urinarnih infekcija se zasniva na mikrobiološkim nalazima, kliničkoj slici, i karakteristikama pacijenta. Empirijska terapija se često započinje sa antibioticima kao što su nitrofurantoin ili trimetoprim-sulfametoksazol, dok se kod komplikovanih slučajeva može koristiti širi spektar antibiotika.
Principi lečenja uključuju:
- Empirijsku terapiju zasnovanu na lokalnim epidemiološkim podacima
- Prilagođavanje terapije na osnovu antibiograma
- Razmatranje specifičnih okolnosti kao što su trudnoća ili prisustvo katetera
Ukupno trajanje lečenja varira, obično između 3-14 dana, u zavisnosti od težine i lokalizacije infekcije.
Infekcije identifikovane brisevima – dijagnostika i lečenje
Pravilna dijagnostika i lečenje infekcija identifikovanih brisevima zahtevaju sveobuhvatan pristup koji uključuje mikrobiološke nalaze, kliničku sliku i karakteristike pacijenta. Brisevi se koriste za uzorkovanje različitih lokalizacija, kao što su grlo, nos, vagina ili rane, kako bi se identifikovali uzročnici infekcija.
Klinička slika infekcija različitih lokalizacija
Infekcije identifikovane brisevima mogu se manifestovati na različite načine, zavisno od lokalizacije i vrste mikroorganizama. Na primer, streptokokni faringitis karakteriše se upalom grla, groznicom i prisustvom eksudata na tonzilama. Bakterijska vaginoza se manifestuje kao poremećaj vaginalne flore, praćen neprijatnim mirisom i abnormalnim iscedkom.
Klinička slika može varirati od asimptomatske nosilac bakterije do teških simptoma, što zahteva pažljivu procenu pacijentovog stanja i mikrobioloških nalaza.
Dijagnostički postupci
Dijagnostika infekcija identifikovanih brisevima počinje pravilnim uzorkovanjem materijala. Brisevi se uzimaju iz zahvaćene oblasti i šalju u mikrobiološku laboratoriju na analizu. Mikrobiološka analiza uključuje kultivaciju mikroorganizama, identifikaciju vrsta i testiranje osetljivosti na antibiotike.
Precizna dijagnostika je ključna za odabir adekvatne terapije. Na primer, gonokokni uretritis zahteva kombinovanu terapiju cefalosporinom treće generacije i azitromicinom zbog česte koinfekcije sa hlamidijom i rastuće rezistencije gonokoka na antibiotike.
Terapijski pristup zasnovan na mikrobiološkim rezultatima
Terapijski pristup infekcijama identifikovanim brisevima zasniva se na pravilnoj interpretaciji mikrobioloških rezultata, kliničkoj slici i karakteristikama pacijenta. Na primer, streptokokni faringitis leči se penicilinom ili amoksicilinom tokom 10 dana. Bakterijska vaginoza tretira se metronidazolom ili klindamicinom.
- Streptokokni faringitis: penicilin ili amoksicilin 10 dana
- Bakterijska vaginoza: metronidazol ili klindamicin
- Gonokokni uretritis: cefalosporin treće generacije i azitromicin
- Infekcije rana: prema rezultatima antibiograma, uz lokalnu negu rane
Individualizovani terapijski pristup omogućava efikasnije lečenje i smanjuje rizik od rezistencije mikroorganizama na antimikrobne lekove.
Rezistencija mikroorganizama na antimikrobne lekove
Porast rezistencije mikroorganizama na antimikrobne lekove ugrožava efikasnost medicinskih tretmana širom sveta. Rezistencija na antibiotike nije nov problem, ali je u poslednje vreme dobio na značaju zbog brzog širenja multirezistentnih sojeva.
Mehanizmi razvoja rezistencije
Rezistencija mikroorganizama na antimikrobne lekove razvija se kroz nekoliko mehanizama. Mutacije u genima mikroorganizama mogu promeniti ciljane strukture na koje deluju antimikrobni lekovi, čineći ih manje efikasnim. Pored toga, mikroorganizmi mogu steći gen za rezistenciju kroz horizontalni prenos gena od drugih mikroorganizama.
Drugi mehanizam uključuje aktivne efluks pumpe koje uklanjaju antimikrobne lekove iz ćelije, čime se smanjuje njihova efikasnost. Takođe, neki mikroorganizmi proizvode enzime koji inaktiviraju antimikrobne lekove, kao što su beta-laktamaze koje razgrađuju beta-laktamske antibiotike.
Multirezistentni mikroorganizmi
Multirezistentni mikroorganizmi predstavljaju veliki izazov u zdravstvenim ustanovama i van njih. Ovi mikroorganizmi su rezistentni na više klasa antimikrobnih lekova, što značajno ograničava mogućnosti lečenja. Metoksiilin-rezistentni Staphylococcus aureus (MRSA) i karbapenem-rezistentne Enterobacteriaceae (CRE) su primeri takvih mikroorganizama koji su postali značajan problem u kliničkoj praksi.
- MRSA je čest uzročnik bolničkih infekcija i može izazvati teške infekcije kože, pluća i krvi.
- CRE su rezistentne na većinu dostupnih antibiotika, što čini lečenje teškim i komplikovanim.
Strategije prevazilaženja rezistencije
Da bi se prevazišla rezistencija mikroorganizama na antimikrobne lekove, potrebna je višestruka strategija. Jedan od pristupa je racionalna upotreba antibiotika, što uključuje primenu pravog antibiotika u pravoj dozi i u pravo vreme, samo kada je to medicinski indikovano.
Drugi važan pravac je razvoj novih antimikrobnih lekova i alternativnih terapijskih pristupa, kao što su bakteriofagi i antimikrobni peptidi. Pored toga, unapređenje dijagnostičkih metoda omogućava brzu identifikaciju uzročnika i određivanje njihove osetljivosti na antimikrobne lekove, što omogućava ciljanu terapiju.
Edukacija zdravstvenih radnika i podizanje svesti javnosti o problemu antimikrobne rezistencije su ključni za dugoročno očuvanje efikasnosti postojećih antibiotika.
Mikrobiologija igra ključnu ulogu u prevenciji i kontroli infekcija u zdravstvenim ustanovama. Njena primena omogućava identifikaciju i karakterizaciju mikroorganizama koji uzrokuju infekcije, što je ključno za odabir adekvatne terapije i prevenciju daljeg širenja infekcija.
Uloga mikrobioloških analiza u prevenciji bolničkih infekcija
Mikrobiološke analize su neophodne za praćenje prisustva i karakteristika mikroorganizama u bolničkoj sredini. Ove analize omogućavaju rano otkrivanje potencijalnih izvora infekcija i implementaciju mera za njihovo suzbijanje. Praćenje prevalencije i obrazaca rezistencije bakterija izolovanih iz kliničkih uzoraka omogućava kreiranje lokalnih mapa rezistencije i smernica za empirijsku antibiotsku terapiju.
Mikrobiološki monitoring u zdravstvenim ustanovama
Mikrobiološki monitoring predstavlja sistematsko praćenje prisustva i karakteristika mikroorganizama u bolničkoj sredini, kod pacijenata i zdravstvenih radnika. Ovaj monitoring uključuje epidemiološki nadzor nad bolničkim infekcijama, identifikaciju uzročnika, molekularnu tipizaciju izolata i utvrđivanje puteva prenosa, što je ključno za kontrolu epidemija.
Značaj pravilne interpretacije mikrobioloških rezultata
Pravilna interpretacija mikrobioloških rezultata je od suštinskog značaja za efikasnu prevenciju i kontrolu infekcija. Rezultati mikrobiološkog monitoringa koriste se za evaluaciju efikasnosti programa prevencije i kontrole infekcija, identifikaciju problema i implementaciju korektivnih mera. Pravilna interpretacija omogućava zdravstvenim radnicima da donesu informisane odluke o terapiji i prevenciji infekcija.
U zaključku, mikrobiologija je nezamenljiva u prevenciji i kontroli infekcija. Njena uloga u mikrobiološkom monitoringu, pravilnoj interpretaciji rezultata i prevenciji bolničkih infekcija je od vitalnog značaja za bezbednost pacijenata i zdravstvenih radnika.
